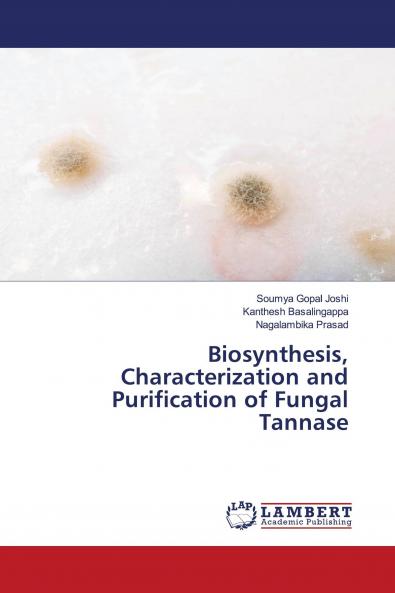
Biosynthesis Characterization and Purification of Fungal Tannase

English
Paperback
₹3363
₹3540
5% OFF
(All inclusive*)
Delivery Options
Please enter pincode to check delivery time.
*COD & Shipping Charges may apply on certain items.
Review final details at checkout.
Looking to place a bulk order? SUBMIT DETAILS
About The Book
Description
Author
Tannase or tannin acyl hydrolase (E.C. 3.1.1.20) is an industrially necessary enzyme used in the food and pharmaceutical industry as well as in bioremediation processes. Fungi are one of the large producers of tannase among all microbes. Aspergillus alliaceous a newly isolated fungal strain from the soil sample identified to produce tannase enzyme. Under optimized conditions maximum tannase was produced by the submerged fermentation method. Tannase enzyme was produced in a selective medium called Czapek-Dox’s minimal medium supplemented with tannic acid as a carbon source. Parameters of the culture namely pH temperature inoculum size were optimized for tannase production. Maximum production of the tannase was seen at 6.0 pH 300C incubation temperature and 0.5ml of inoculum size after 96hours of incubation time. The produced tannase was purified partially by the ammonium sulphate salt precipitation and dialysis. Enzyme with partial purification was subjected to the characterization of the enzyme. The characterization of the enzyme includes the effect of pH temperature temperature stability and substrate on the enzyme.
Delivery Options
Please enter pincode to check delivery time.
*COD & Shipping Charges may apply on certain items.
Review final details at checkout.
Details
ISBN 13
9786203580259
Publication Date
-18-03-2021
Pages
-76
Weight
-116 grams
Dimensions
-150x220x4.5 mm